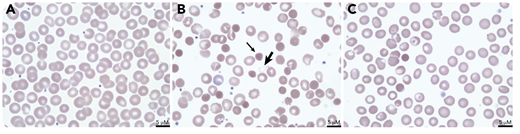
A term male infant with aortic coarctation developed neonatal necrotizing enterocolitis on day of life (DOL) 6 requiring bowel resection and peritoneal washout. On DOL7, he developed jaundice and dark-colored urine with a decreasing hemoglobin level (12.3 to 10.6 g/dL) and an increased reticulocyte count (260 × 109/L; 7.3%). Plasma hemoglobin was >500 mg/dL and lactic acid dehydrogenase was 1124 units/L. Review of a peripheral blood smear from DOL5 showed unremarkable red blood cell (RBC) morphology (panel A: 100× objective, ×50 total magnification). The smear on DOL7 demonstrated abundant dense microspherocytes (thin arrow; panel B: 100× objective, ×50 total magnification). Peritoneal fluid cultures grew Clostridium perfringens. Antibiotic treatment was initiated, and the patient’s intravascular hemolysis stabilized. Repeat smear on DOL9 demonstrated improvement in spherocytosis (panel C: 100× objective, ×50 total magnification).

A term male infant with aortic coarctation developed neonatal necrotizing enterocolitis on day of life (DOL) 6 requiring bowel resection and peritoneal washout. On DOL7, he developed jaundice and dark-colored urine with a decreasing hemoglobin level (12.3 to 10.6 g/dL) and an increased reticulocyte count (260 × 109/L; 7.3%). Plasma hemoglobin was >500 mg/dL and lactic acid dehydrogenase was 1124 units/L. Review of a peripheral blood smear from DOL5 showed unremarkable red blood cell (RBC) morphology (panel A: 100× objective, ×50 total magnification). The smear on DOL7 demonstrated abundant dense microspherocytes (thin arrow; panel B: 100× objective, ×50 total magnification). Peritoneal fluid cultures grew Clostridium perfringens. Antibiotic treatment was initiated, and the patient’s intravascular hemolysis stabilized. Repeat smear on DOL9 demonstrated improvement in spherocytosis (panel C: 100× objective, ×50 total magnification).
Clostridial sepsis can cause profound intravascular hemolysis and should be considered in patients at risk of anaerobic infection, such as with necrotizing enterocolitis, typhlitis, or abdominal penetrating trauma. C perfringens is an anaerobic, gram-positive, spore-forming rod. It secretes α toxin, a phospholipase enzyme that damages RBC membranes leading to intravascular hemolysis and microspherocytosis. “Ghosts,” RBCs depleted of hemoglobin, can be seen (thick arrow, panel B), but are cleared rapidly from the circulation. Treatment of hyperbilirubinemia is supportive; hemolysis resolves with source control and antibiotics.
A term male infant with aortic coarctation developed neonatal necrotizing enterocolitis on day of life (DOL) 6 requiring bowel resection and peritoneal washout. On DOL7, he developed jaundice and dark-colored urine with a decreasing hemoglobin level (12.3 to 10.6 g/dL) and an increased reticulocyte count (260 × 109/L; 7.3%). Plasma hemoglobin was >500 mg/dL and lactic acid dehydrogenase was 1124 units/L. Review of a peripheral blood smear from DOL5 showed unremarkable red blood cell (RBC) morphology (panel A: 100× objective, ×50 total magnification). The smear on DOL7 demonstrated abundant dense microspherocytes (thin arrow; panel B: 100× objective, ×50 total magnification). Peritoneal fluid cultures grew Clostridium perfringens. Antibiotic treatment was initiated, and the patient’s intravascular hemolysis stabilized. Repeat smear on DOL9 demonstrated improvement in spherocytosis (panel C: 100× objective, ×50 total magnification).
Clostridial sepsis can cause profound intravascular hemolysis and should be considered in patients at risk of anaerobic infection, such as with necrotizing enterocolitis, typhlitis, or abdominal penetrating trauma. C perfringens is an anaerobic, gram-positive, spore-forming rod. It secretes α toxin, a phospholipase enzyme that damages RBC membranes leading to intravascular hemolysis and microspherocytosis. “Ghosts,” RBCs depleted of hemoglobin, can be seen (thick arrow, panel B), but are cleared rapidly from the circulation. Treatment of hyperbilirubinemia is supportive; hemolysis resolves with source control and antibiotics.
For additional images, visit the ASH Image Bank, a reference and teaching tool that is continually updated with new atlas and case study images. For more information, visit http://imagebank.hematology.org.
This feature is available to Subscribers Only
Sign In or Create an Account Close Modal